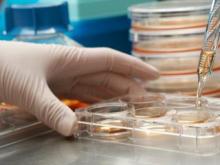
Родители верят в чудо

Гурьева – Фаттахов: кто кого одолеет?
Избирательная кампания по выборам в горсовет Набережных Челнов обещает быть острой по крайней мере в нескольких округах. Лидеру местных «Коммунистов России» единороссы противопоставили руководителя отделения Пенсионного фонда. Сергею Еретнову придется бороться с Сергеем Яковлевым из-под домашнего ареста. А гендиректору целой группы компаний «ьросает перчатку» пенсионерка.
Девушка из Набережных Челнов на параде шлепала в резиновых тапочках
Студентка Эльмира Ахметзянова приняла участие в церемонии открытия чемпионата мира по водным видам спорта в Казани. Она рассказала «Челны ЛТД» о том, как туда попала, кто их готовил проводить церемонию и какой косметикой они были вынуждены пользоваться.
Профессия года – стоматолог
Приемные комиссии колледжей и техникумов Набережных Челнов отмечают рост числа абитуриентов. По статистике горисполкома, сегодня 52% выпускников 9-х классов выбирают для дальнейшего обучения эти заведения. Несколько лет назад их выбирали лишь 15%. Редакция «Челны ЛТД» поинтересовалась, какие специальности наиболее популярны у молодежи.